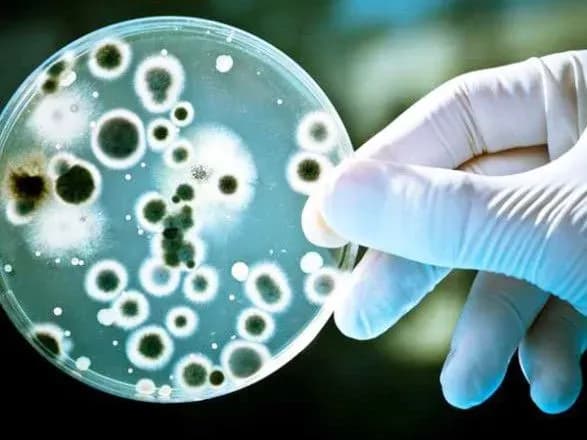
den-narodzhennya-penitsilinu-den-pozitivnogo-mislennya-scho-sche-mozhna-vidznachiti-13-veresnya

Шотландський мікробіолог Олександр Флемінг досліджував різні культури гноєтворних бактерій. Він розмістив їх у відкритих чашках Петрі напередодні літніх канікул.
Коли повернувся, то побачив, що у деяких чашках завелася пліснява.
Вважається, що саме 13 вересня 1928 року Флемінг дійшов висновку, що в одній з чашок пліснява пригнічує ріст бактерій. Це була зелена кистеподібна пліснява Penicillium notatum.
Флемінг продовжив свої експерименти. “Ворожу” бактеріям речовину, яку виділяла пліснява, Флемінг назвав пеніциліном.
Цікаво, що вчений не спробував виділити пеніцилін у чистому вигляді, і, взагалі, не надав уваги своєму відкриттю.
Флемінг у 1929 році лише опублікував статтю в науковому журналі. Нею зацікавилися вчені Говард Волтер Флорі та Ернест Борис Чейн.
Вони провели випробування пеніциліну на тваринах, які показали чудові результати його протидії інфекціям.
У 1941 році в США почалося масове виробництво пеніциліну за державним замовленням. Одним з ключових підрядників була компанія Pfizer, яка до того часу, взагалі, не займалася медикаментами, а спеціалізувалася на виробництві лимонної кислоти.
Також сьогодні можна відзначити День позитивного мислення.
Ця неофіційна подія була започаткована у 2003 році. Ії мета — пропаганда ідеї про те, що негативні думки приносять більше шкоди, ніж користі, вони виснажують, відбирають енергію. А позитивне мислення має прямий зв’язок зі здатністю підтримувати в собі надію та зацікавленість незважаючи на події, позитивні чи негативні.
13 вересня — це ще й День дядька Сема — вигаданого персонажа, що уособлює США.
Хоча у цього персонажа є свій реальний прототип — підприємець Сем Вілсон, який народився 13 вересня 1776 року.
Вілсон постачав м’ясо до однієї з військових частин американської армії. На бочках з ним він ставив маркування “U.S”, маючи на увазі Сполучені Штати. Але хтось вирішив розшифрувати цю абревіатуру як Uncle Sam.
Візуальний образ дядька Сема вперше з’явився в одній з американських газет у 1952 році. Його автором був художник-карикатурист Френк Генрі Белл.
Дядька Сема він зобразив високим, худим, літнім чоловіком зі старомодною бородою, в капелюсі-циліндрі в кольорах національного прапору, смугастих штанях та синьому піджаку.
За церковним календарем сьогодні День пам’яті святого Корнилія.
Корнилій жив у І столітті у Кесарії, був римським воїном та язичником.
За переказом, якось чоловіку явився янгол, який наказав знайти апостола Петра. Корнилій послухався і виконав наказ. Він зустрівся з апостолом та привів його до свого дому. Після розповіді Петра про вчення Христа Корнилій увірував та вирішив прийняти хрещення.
Згодом Петро висвятив Корнилія на єпископа. Якось у Скепсії Корнилій зайшов до язичницького храму, який після його після його проповіді розвалився. Усі місцеві мешканці одразу прийняли християнство.
Після смерті Корнилія поховали біля руїн цього язичницького храму.
Іменини сьогодні святкують Олександр, Володимир, Геннадій, Дмитро, Мирон.